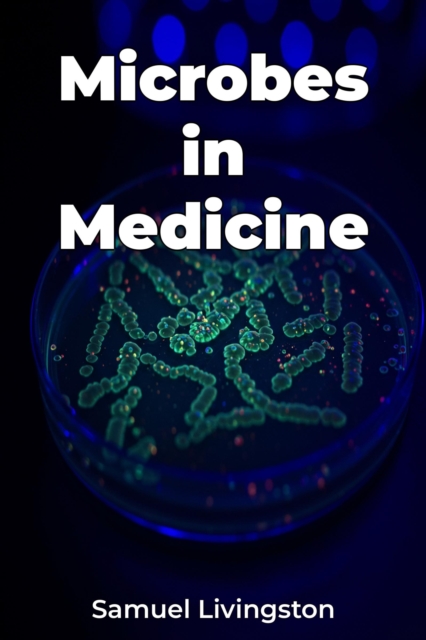
Microbes in Medicine

Microbes in Medicine
"Microbes in Medicine" explores the groundbreaking role of microorganisms in modern healthcare, revealing how these tiny entities are not just agents of disease but powerful tools for creating antibiotics, developing vaccines, and pioneering microbial therapies. The book highlights the evolution of vaccine development, from traditional methods to cutting-edge mRNA technologies, showcasing how our ...
"Microbes in Medicine" explores the groundbreaking role of microorganisms in modern healthcare, revealing how these tiny entities are not just agents of disease but powerful tools for creating antibiotics, developing vaccines, and pioneering microbial therapies. The book highlights the evolution of vaccine development, from traditional methods to cutting-edge mRNA technologies, showcasing how our ...
